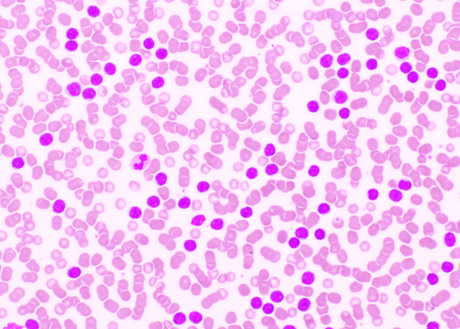

FDA approves revumenib for relapsed or refractory acute leukemia with a KMT2A translocation
What is the potential role for revumenib in the treatment of relapsed or refractory (R/R) acute leukemia?
- Revumenib is an oral, first-in-class, small molecule inhibitor of the menin-lysine methyltransferase 2A (KMT2A) interaction in acute leukemias (AL) harboring a KMT2A-rearranged (KMT2Ar) translocation.
- A KMT2Ar translocation leads to oncogenic fusion proteins that upregulate leukemogenic homeobox (HOX) genes and their DNA-binding cofactor Meis homeobox 1 (MEIS1).
- Menin is a scaffolding protein that is essential to binding of the KMT2A protein complex to the HOX gene promoter, making it a crucial mediator of the pathogenesis of KMT2Ar AL.
- In non-clinical in vitro and in vivo studies, revumenib demonstrated antiproliferative and antitumor activity in leukemia cells harboring KMT2Ar translocation by disrupting the menin-KMT2A interaction.1
- Revumenib is FDA approved for the treatment of R/R AL with a KMT2Ar translocation in adult and pediatric patients ≥ 1 years of age based on data collected from the ongoing single-arm cohort of the open-label, multicenter phase I/II AUGMENT-101 trial.2
- AUGMENT-101 included heavily pre-treated adult and pediatric patients ≥30 days old (n = 97) with primary R/R KMT2Ar AL.2,3
- Revumenib is a substrate of cytochrome P450 3A4 (CYP3A4), and the investigational dose used with a concomitant strong CYP3A4 inhibitor (CYP3A4i) was 163 mg (95 mg/m2 if <40 kg) once every 12 hours or 276 mg (160 mg/m2 if <40 kg) once every 12 hours without a strong CYP3A4i.1
- The main efficacy outcome measures were complete remission (CR) plus CR with partial hematologic recovery (CRh) and the duration of CR+CRh.
- As of February 29, 2024, 22/97 patients achieved CR+CRh (23%) with a median duration of 13 months (95% confidence interval [CI], 1.9 months not reached [NR]) for these patients.
- Composite CR [CRc] rate was 42% (95% CI, 32%-53%), defined as CR + CRh + complete remission with incomplete hematologic recovery [CRi] + complete remission with incomplete platelet recovery [CRp].
- Overall response rate was 64% (95% CI, 54%-73%).
- Of 18 CR+CRh responders with minimal residual disease [MRD] results available, 11 (61%) achieved MRD negativity; 21/36 (58%) MRD-evaluable CRc responders achieved MRD negativity.
- Revumenib’s adverse events led to dose interruptions in 43.6%, discontinuation in 12.8%, and death in 14.9% of patients; however, no patients discontinued revumenib because of prolongation of QTc interval or differentiation syndrome.2,3
- The National Comprehensive Cancer Network (NCCN) recommends the consideration of revumenib as targeted therapy for KMT2A-rearranged (KMT2Ar) R/R AL such as acute myeloid leukemia (AML), acute lymphoblastic leukemia (ALL), specifically Philadelphia-negative B-cell ALL, and T-cell ALL.4,5
- AUGMENT-101 also aimed to understand revumenib’s role in acute leukemias with a nucleophosmin 1 (NPM1) mutation as there is a shared dependency on the menin-KMT2A interaction.
- NPM1 is the most common genetic alteration in adults with AML, and the AUGMENT-101 study is ongoing in its evaluation of this mutation.2
- There are currently multiple phase I and II studies investigating revumenib in combination with FLT3 inhibitors (e.g., gilteritinib, midostaurin), chemotherapy (e.g., fludarabine, cytarabine), and in leukemias with genetic alterations associated with upregulation of HOX.6
- Given the high mortality rate associated with R/R AL, revumenib offers a novel and promising avenue to improve survival in this patient population. There is no comparative efficacy to compare the use of revumenib as this is a first-in-class medication.2 Assessment of the risks, benefits, and incidence of adverse effects of the use of revumenib should guide treatment decisions.
What role can the pharmacist play in the management of patients on revumenib?
- Pharmacists can play a role in the management of patients on revumenib by ensuring appropriate dosing and dose reductions, management of side effects, adherence, and accessibility.
- Dosing and Administration
- Appropriate dosing and respective dose reductions for toxicities are based on the utilization of a concomitant strong CYP3A4i (Table 1) and on body surface area for patients <40 kg in weight (Table 2).
- Recommendations for toxicity management can be found in Table 3.1



- Revumenib is currently available as 25 mg, 110 mg, and 160 mg oral tablets.
- Tablets should be swallowed whole; however, for patients unable to swallow whole, the appropriate number of tablets for the prescribed dose may be crushed, dispersed in water, and administered within 2 hours of preparation.
- May be taken either in a fasted state or with a low-fat meal (~400 calories, ≤25% fat).
- If a patient misses a dose by more than 12 hours, advise the patient to skip the dose and administer the next dose at the scheduled time.
- There are no dose modifications for renal dysfunction.
- There are no dose modifications for hepatic dysfunction.
Adverse Effects
- Based on the results from the AUGMENT-101 trial, serious adverse events include febrile neutropenia (all grades: 35%; grades 3/4: 33%), differentiation syndrome (all grades: 29%; grades 3/4: 13%), infections (all grades: 41%; grades 3/4: 29%), and QTc prolongation (all grades: 29%; grades 3/4: 12%).
- Vascular disorders adverse events include hemorrhage (all grades: 53%; grades 3/4: 9%) and thrombosis (all grades: 10%; grades 3/4: 5%).
- Gastrointestinal disorders adverse events include nausea (all grades: 51%; grades 3/4: 4%), diarrhea (all grades: 30%; grades 3/4: 4%), and constipation in (all grades: 23%; grades 3/4: 1%).
- Baseline Monitoring
- Genetic testing to assess for KMTA translocation status.
- Complete blood count (CBC).
- Comprehensive metabolic panel (CMP).
- Electrocardiogram (ECG).
- Pregnancy status.
- Regular Monitoring
- CBC
- CMP
- ECG at least once weekly during the first 4 weeks, then at least monthly thereafter (more frequent ECG monitoring may be necessary in patients with congenital long QTc syndrome, heart failure, electrolyte abnormalities, or those who are taking medications known to prolong the QTc interval).
- Signs/symptoms of differentiation syndrome, hypersensitivity, and/or QTc prolongation.
- Bone growth and development in pediatric patients.
- Adherence.
- Revumenib is a substrate of CYP3A4 (major).1
Clinical Pearls
- In the AUGMENT-101 trial, all patients in the study utilized a concomitant azole strong CYP3A4i.
- Most patients in the AUGMENT-101 trial had received ≥3 prior lines of therapy including venetoclax, and some patients had undergone prior allogeneic hematopoietic cell transplantation.
- Although the study was not powered for subgroup analyses, the reported subgroup analysis for AUGMENT-101 showed a trend for better CR+CRh rates in patients with only one prior line of therapy and in patients with no prior exposure to venetoclax.2
- Patients who could become pregnant and patients with partners who could become pregnant should use effective contraception during therapy and for 4 months after the last revumenib dose.
- The dosage form and available product strengths are different than investigational supply with no commercially available oral solution currently.
- Currently, there is an Expanded Access Program for the oral solution available at this link.7
- Revumenib tablets should be stored at 20°C to 25°C (68°F to 77°F); excursions permitted between 15°C to 30°C (59°F to 86°F).1
- Syndax provides a program called the “SyndAccess™ Patient Support Program” that may provide financial assistance if eligible commercially insured patients need assistance with their out-of-pocket costs.8
References
1.Revumenib [package insert]. U.S. Food and Drug Administration website. https://www.accessdata.fda.gov/drugsatfda_docs/label/2024/218944s000lbl.pdf. Revised [11/2024]. Accessed [2/5/2025].
2.Issa GC, Aldoss I, Thirman MJ, et al. Menin inhibition with revumenib for KMT2Arearranged relapsed or refractory acute leukemia (AUGMENT-101). J Clin Oncol 2024:JCO2400826.
3.Aldoss I, et al. "Updated Results and Longer Follow-up from the AUGMENT-101 Phase 2 Study of Revumenib in All Patients with Relapsed or Refractory (R/R) KMT2Ar Acute Leukemia." Blood 144 (2024): 211.
4.National Comprehensive Cancer Network. Acute Myeloid Leukemia. (Version 2.2025 — January 27, 2025). https://www.nccn.org/professionals/physician_gls/pdf/aml.pdf. Accessed January 5, 2025.
5.National Comprehensive Cancer Network. Acute Lymphoblastic Leukemia. (Version 3.2024 — December 20, 2024). https://www.nccn.org/professionals/physician_gls/pdf/all.pdf. Accessed January 5, 2025.
6.Clinical Trials Using Revumenib. National Cancer Institute. National Institute of Health. Accessed January 5, 2025.
7.Expanded Access Program (EAP) for Revumenib. ClinicalTrials.gov ID NCT05918913. National Institute of Health.
8.Revuforj (Revumenib) – Information for Patients. https://syndaccess.com/hcp/